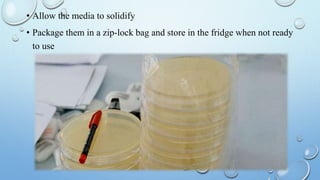
• Allow the media to solidify
• Package them in a zip-lock bag and store in the fridge when not ready
to use

Culture medium is a substance used to grow microorganisms outside the body. It provides nutrients, minerals, and other factors necessary for microbial growth. There are various types of culture media classified by physical state (solid, semi-solid, liquid) and ingredients (simple, complex, synthetic). Common media include nutrient agar, used for general microbial growth, and Mueller Hinton agar, recommended for antibiotic susceptibility testing due to its reproducibility. Media preparation involves accurately weighing ingredients, dissolving them in water, sterilizing the mixture, and pouring it into plates to solidify.